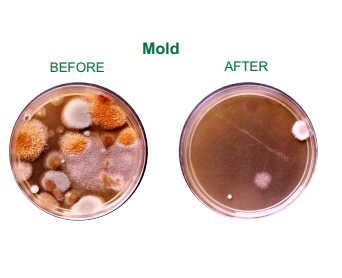

The patented Element Air treatment systems are the most practical and effective solution for airborne and surface microbial contaminants, including powdery mildew, total yeast and mold (TYM). Element Air has been independently verified to reduce bacterial and other microbial contaminants by +-99% via photohydrioionization (PHI) technology.
The Element Air Wall Mount Purification System Reduces:
The Element Air Wall Mount Purification System Applications:
Most cultivation and extraction facilities do not check the air for microorganisms on a daily or monthly basis. Bacteria and mold can continuously breed within the environment, plants, and finished product, including extracts. RGF developed Element Air treatment system to provide continuous protection in sensitive air spaces.
Air passes through a REME ® / PHI oxidation chamber, which destroys airborne microbes with high intensity UV light rays targeted on a quad-metallic compound. The process develops a highly charged atmosphere of hydroxyl radicals, hydro-peroxides and super oxide ions. This atmosphere oxidizes contaminants in the air with friendly oxidizers. By friendly oxidizers, we mean oxidizers that revert back to oxygen and hydrogen after the oxidation process. No chemical residue or dangerous compounds are emitted from the system. Airborne contaminants in the form of bacteria, mold, and yeast continue to be one of the least addressed issues in most facilities.
The Element Air technology utilizes broad spectrum, high-intensity UV lights targeted on a hydrated quad-metallic catalyst which utilizes ambient moisture to generate hydro-peroxides and hydroxides that are propelled into the cultivation facility, to provide active microbial and odor mitigation. The unit was designed for grow house applications and does not emit any visible light allowing the unit to run 24/7.
* This Element Air unit is recommended to be placed in a room no smaller than 2,000 cubic feet (Square feet times ceiling height). This Element Air unit has the potential to create high levels of ozone. The ozone levels will depend on the level of microorganisms or contaminants in the space. Ozone will revert to oxygen when it encounters a contaminant. Due to this reaction, ozone levels will always be lower when the levels of contaminants are high and vice versa. An ozone monitor is recommended to ensure safe levels.